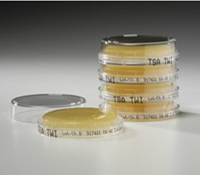

供应饲料级自溶粉
我公司生产的自溶酵母粉选用特异鲜酵母为原料,采用高效破壁和多联酶解等高新技术,经提纯精制而成。产品富含核苷酸,营养小肽、谷胱甘肽及酵母细胞壁多糖等多种营养成分,不含载体,耐高温、可制粒。对动物具有极佳的诱食性、免疫性和促生长性。适用于水产、畜禽及宠物饲料。
我公司生产的自溶酵母粉具有强烈的诱食性,可增强乳禽料和水产饲料的适口性及动物采食量。自溶酵母粉能够改善畜禽消化道微生态区系,促进有益菌增殖,降低胃肠道疾病发生率。自溶酵母粉富含功能性小肽及多种酵素,消化吸收率高,可有效提高饲料利用率。自溶酵母粉富含核苷酸、活性肽及免疫多糖等活性成分,可显著提高动物的非特异性免疫力,增强抗病力。
质量标准:
项目
酵母精粉指标
色泽
浅黄色至褐色
气味
具有酵母特殊的气味,无异臭味
水分,%
≤6.0
粗蛋白(以干基计),%
≥45.0
粗灰分,%
≤15.0
粗纤维,%
≤1.5
细胞数,亿个/克
——
砷(以总As计)mg/kg
≤10.0
铅,mg/ke
≤10.0
细菌总数,CFU/g(ml)
≤2*10^6
沙门氏菌,mg/kg
不得检出
三聚氰胺,mg/kg
≤2.5
公司秉承“以质量求效益”的宗旨,诚信经营,以纯正的酵母自溶粉服务于广大客户!

*您的姓名:
*联系手机:
固话电话:
E-mail:
所在单位:
需求数量:
*咨询内容: